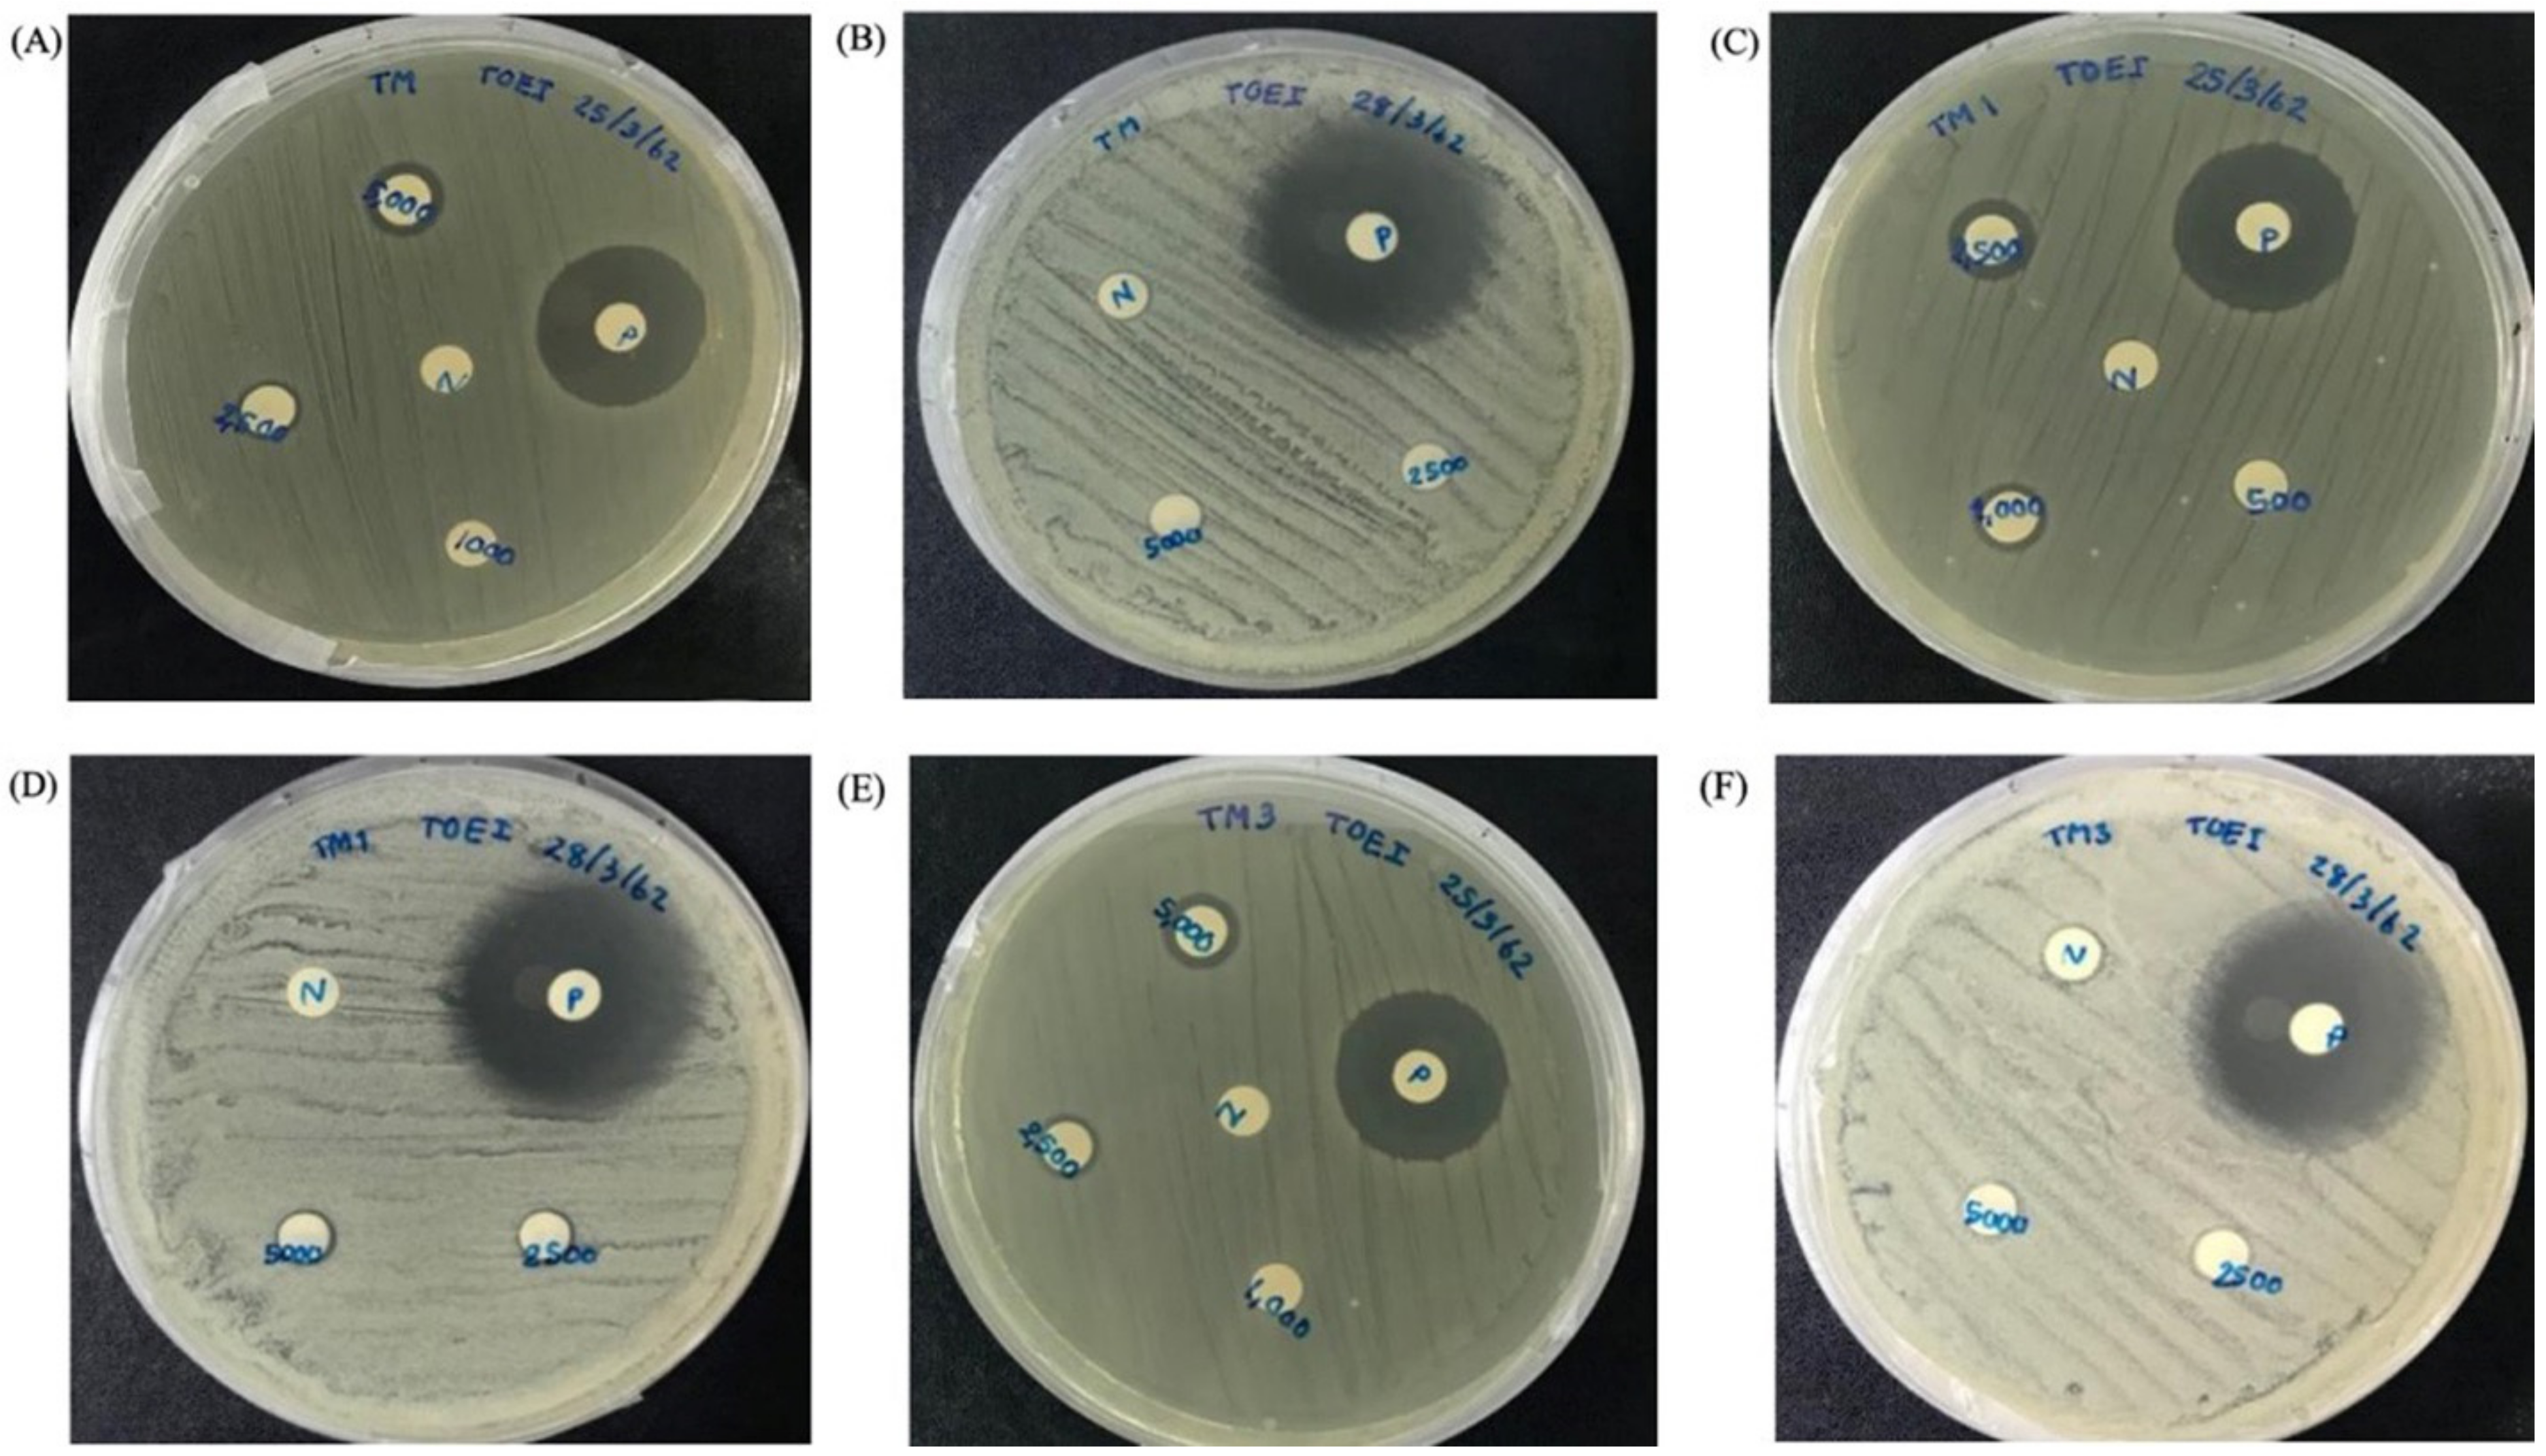
Molecules 27 00561 g005

In Silico and In Vitro Structure–Activity Relationship of Mastoparan and Its Analogs
Abstract
:1. Introduction
2. Results
2.1. Purified Peptides and Peptides Synthesis
2.2. The Partial cDNA Cloning and Sequence Comparison
2.3. Physicochemical Properties and Secondary Structure of MpVT and Its Analogs
2.4. The Secondary Structure Evaluation
2.5. Structural Analysis
2.6. Antibacterial Activity
2.7. Time–Kill Assay
2.8. Hemolytic Activity
3. Discussion
4. Materials and Methods
4.1. Peptides Synthesis and Purification
4.2. cDNA Cloning and Sequence Comparison
4.3. Molecular Modeling
4.4. Determination of Minimum Inhibitory Concentration (MIC)
O.D.600 at immediate treatment of control).
4.5. Hemolysis Activity
4.6. Secondary Structure Evaluation through Circular Dichroism (CD)
4.7. Scanning Electron Microscopy (SEM)
4.8. Time–Kill Assay
4.9. Statistical Analysis
5. Conclusions
Supplementary Materials
Author Contributions
Funding
Acknowledgments
Conflicts of Interest
Sample Availability
References
- Memariani, H.; Shahbazzadeh, D.; Ranjbar, R.; Behdani, M.; Memariani, M.; Pooshang Bagheri, K. Design and characterization of short hybrid antimicrobial peptides from pEM-2, mastoparan-VT1, and mastoparan-B. Chem. Biol. Drug Des. 2017, 89, 327–338. [Google Scholar] [CrossRef]
- Uawonggul, N.; Thammasirirak, S.; Chaveerach, A.; Arkaravichien, T.; Bunyatratchata, W.; Ruangjirachuporn, W.; Jearranaiprepame, P.; Nakamura, T.; Matsuda, M.; Kobayashi, M.; et al. Purification and characterization of Heteroscorpine-1 (HS-1) toxin from Heterometrus laoticus scorpion venom. Toxicon 2007, 49, 19–29. [Google Scholar] [CrossRef]
- Cesa-Luna, C.; Muñoz-Rojas, J.; Saab-Rincon, G.; Baez, A.; Morales-García, Y.E.; Juárez-González, V.R.; Quintero-Hernández, V. Structural characterization of scorpion peptides and their bactericidal activity against clinical isolates of multidrug-resistant bacteria. PLoS ONE 2019, 14, e0222438. [Google Scholar] [CrossRef] [Green Version]
- Kang, X.; Dong, F.; Shi, C.; Liu, S.; Sun, J.; Chen, J.; Li, H.; Xu, H.; Lao, X.; Zheng, H. DRAMP 2.0, an updated data repository of antimicrobial peptides. Sci. Data 2019, 6, 148. [Google Scholar] [CrossRef] [PubMed] [Green Version]
- Wang, G.; Li, X.; Wang, Z. APD2: The updated antimicrobial peptide database and its application in peptide design. Nucleic Acids Res. 2009, 37, D933–D937. [Google Scholar] [CrossRef] [Green Version]
- Irazazabal, L.N.; Porto, W.F.; Ribeiro, S.M.; Casale, S.; Humblot, V.; Ladram, A.; Franco, O.L. Selective amino acid substitution reduces cytotoxicity of the antimicrobial peptide mastoparan. Biochim. Biophys. Acta (BBA) Biomembr. 2016, 1858, 2699–2708. [Google Scholar] [CrossRef]
- Rungsa, P.; Incamnoi, P.; Sukprasert, S.; Uawonggul, N.; Klaynongsruang, S.; Daduang, J.; Patramanon, R.; Roytrakul, S.; Daduang, S. Comparative proteomic analysis of two wasps venom, Vespa tropica and Vespa affinis. Toxicon 2016, 119, 159–167. [Google Scholar] [CrossRef]
- Srisong, H.; Daduang, S.; Lopata, A.L. Current advances in ant venom proteins causing hypersensitivity reactions in the Asia-Pacific region. Mol. Immunol. 2016, 69, 24–32. [Google Scholar] [CrossRef]
- dos Santos-Pinto, J.R.A.; Perez-Riverol, A.; Lasa, A.M.; Palma, M.S. Diversity of peptidic and proteinaceous toxins from social Hymenoptera venoms. Toxicon 2018, 148, 172–196. [Google Scholar] [CrossRef] [PubMed] [Green Version]
- Sukprasert, S.; Rungsa, P.; Uawonggul, N.; Incamnoi, P.; Thammasirirak, S.; Daduang, J.; Daduang, S. Purification and structural characterisation of phospholipase A1 (Vespapase, Ves a 1) from Thai banded tiger wasp (Vespa affinis) venom. Toxicon 2013, 61, 151–164. [Google Scholar] [CrossRef] [PubMed]
- Sookrung, N.; Wong-din-dam, S.; Tungtrongchitr, A.; Reamtong, O.; Indrawattana, N.; Sakolvaree, Y.; Visitsunthorn, N.; Manuyakorn, W.; Chaicumpa, W. Proteome and Allergenome of Asian Wasp, Vespa affinis, Venom and IgE Reactivity of the Venom Components. J. Proteome Res. 2014, 13, 1336–1344. [Google Scholar] [CrossRef] [PubMed]
- Xu, X.; Yang, H.; Yu, H.; Li, J.; Lai, R. The mastoparanogen from wasp. Peptides 2006, 27, 3053–3057. [Google Scholar] [CrossRef]
- Palma, M.S. Hymenoptera Insect Peptides. In Handbook of Biologically Active Peptides, 2nd ed.; Kastin, A.J., Ed.; Academic Press: Boston, MA, USA, 2013; pp. 416–422. [Google Scholar] [CrossRef]
- Da Silva, A.M.B.; Silva-Gonçalves, L.C.; Oliveira, F.A.; Arcisio-Miranda, M. Pro-necrotic Activity of Cationic Mastoparan Peptides in Human Glioblastoma Multiforme Cells Via Membranolytic Action. Mol. Neurobiol. 2018, 55, 5490–5504. [Google Scholar] [CrossRef]
- de Souza, B.M.; da Silva, A.V.; Resende, V.M.; Arcuri, H.A.; Dos Santos Cabrera, M.P.; Ruggiero Neto, J.; Palma, M.S. Characterization of two novel polyfunctional mastoparan peptides from the venom of the social wasp Polybia paulista. Peptides 2009, 30, 1387–1395. [Google Scholar] [CrossRef]
- Lin, C.H.; Tzen, J.T.; Shyu, C.L.; Yang, M.J.; Tu, W.C. Structural and biological characterization of mastoparans in the venom of Vespa species in Taiwan. Peptides 2011, 32, 2027–2036. [Google Scholar] [CrossRef]
- Yang, X.; Wang, Y.; Lee, W.H.; Zhang, Y. Antimicrobial peptides from the venom gland of the social wasp Vespa tropica. Toxicon 2013, 74, 151–157. [Google Scholar] [CrossRef] [PubMed]
- de Lacorte Singulani, J.; Galeane, M.C.; Ramos, M.D.; Gomes, P.C.; dos Santos, C.T.; de Souza, B.M.; Palma, M.S.; Fusco Almeida, A.M.; Mendes Giannini, M.J.S. Antifungal Activity, Toxicity, and Membranolytic Action of a Mastoparan Analog Peptide. Front. Cell. Infect. Microbiol. 2019, 9, 419. [Google Scholar] [CrossRef]
- Da Silva, A.V.R.; De Souza, B.M.; dos Santos Cabrera, M.P.; Dias, N.B.; Gomes, P.C.; Neto, J.R.; Stabeli, R.G.; Palma, M.S. The effects of the C-terminal amidation of mastoparans on their biological actions and interactions with membrane-mimetic systems. Biochim. Biophys. Acta (BBA) Biomembr. 2014, 1838, 2357–2368. [Google Scholar] [CrossRef] [PubMed] [Green Version]
- Erviana, R.; Saengkun, Y.; Rungsa, P.; Jangpromma, N.; Tippayawat, P.; Klaynongsruang, S.; Daduang, J.; Daduang, S. Novel Antimicrobial Peptides from a Cecropin-Like Region of Heteroscorpine-1 from Heterometrus laoticus Venom with Membrane Disruption Activity. Molecules 2021, 26, 5872. [Google Scholar] [CrossRef] [PubMed]
- Chen, X.; Zhang, L.; Wu, Y.; Wang, L.; Ma, C.; Xi, X.; Bininda-Emonds, O.R.P.; Shaw, C.; Chen, T.; Zhou, M. Evaluation of the bioactivity of a mastoparan peptide from wasp venom and of its analogues designed through targeted engineering. Int. J. Biol. Sci. 2018, 14, 599–607. [Google Scholar] [CrossRef]
- Rungsa, P.; Peigneur, S.; Daduang, S.; Tytgat, J. Purification and biochemical characterization of VesT1s, a novel phospholipase A1 isoform isolated from the venom of the greater banded wasp Vespa tropica. Toxicon 2018, 148, 74–84. [Google Scholar] [CrossRef]
- Eisenberg, D.; Weiss, R.M.; Terwilliger, T.C. The helical hydrophobic moment: A measure of the amphiphilicity of a helix. Nature 1982, 299, 371–374. [Google Scholar] [CrossRef] [PubMed]
- Lai, R.; Liu, H.; Lee, W.H.; Zhang, Y. A novel proline rich bombesin-related peptide (PR-bombesin) from toad Bombina maxima. Peptides 2002, 23, 437–442. [Google Scholar] [CrossRef]
- Louis-Jeune, C.; Andrade-Navarro, M.A.; Perez-Iratxeta, C. Prediction of protein secondary structure from circular dichroism using theoretically derived spectra. Proteins Struct. Funct. Bioinform. 2012, 80, 374–381. [Google Scholar] [CrossRef]
- Anunthawan, T.; Yaraksa, N.; Phosri, S.; Theansungnoen, T.; Daduang, S.; Dhiravisit, A.; Thammasirirak, S. Improving the antibacterial activity and selectivity of an ultra short peptide by hydrophobic and hydrophilic amino acid stretches. Bioorganic Med. Chem. Lett. 2013, 23, 4657–4662. [Google Scholar] [CrossRef]
- Theansungnoen, T.; Maijaroen, S.; Jangpromma, N.; Yaraksa, N.; Daduang, S.; Temsiripong, T.; Daduang, J.; Klaynongsruang, S. Cationic Antimicrobial Peptides Derived from Crocodylus siamensis Leukocyte Extract, Revealing Anticancer Activity and Apoptotic Induction on Human Cervical Cancer Cells. Protein J. 2016, 35, 202–211. [Google Scholar] [CrossRef]
- Walker, A.A. The evolutionary dynamics of venom toxins made by insects and other animals. Biochem. Soc. Trans. 2020, 48, 1353–1365. [Google Scholar] [CrossRef]
- Freire, D.O.; da Cunha, N.B.; Leite, M.L.; Kostopoulos, A.G.C.; da Silva, S.N.B.; de Souza, A.C.B.; Nolasco, D.O.; Franco, O.L.; Mortari, M.R.; Dias, S.C. Wasp venom peptide, synoeca-MP, from Synoeca surinama shows antimicrobial activity against human and animal pathogenic microorganisms. Pept. Sci. 2020, 112, e24141. [Google Scholar] [CrossRef]
- Jalaei, J.; Fazeli, M.; Rajaian, H.; Shekarforoush, S.S. In vitro antibacterial effect of wasp (Vespa orientalis) venom. J. Venom. Anim. Toxins Incl. Trop. Dis. 2014, 20, 1–6. [Google Scholar] [CrossRef] [PubMed] [Green Version]
- An, S.; Chen, L.; Wei, J.F.; Yang, X.; Ma, D.; Xu, X.; Xu, X.; He, S.; Lu, J.; Lai, R. Purification and characterization of two new allergens from the venom of Vespa magnifica. PLoS ONE 2012, 7, e31920. [Google Scholar] [CrossRef] [PubMed] [Green Version]
- Schmidt, J.O.; Yamane, S.; Matsuura, M.; Starr, C.K. Hornet venoms: Lethalities and lethal capacities. Toxicon 1986, 24, 950–954. [Google Scholar] [CrossRef]
- Kularatne, S.A.; Gawarammana, I.B.; de Silva, P.H. Severe multi-organ dysfunction following multiple wasp (Vespa affinis) stings. Ceylon Med. J. 2003, 48, 146–147. [Google Scholar] [CrossRef] [Green Version]
- Schmidt, J.O. Clinical consequences of toxic envenomations by Hymenoptera. Toxicon 2018, 150, 96–104. [Google Scholar] [CrossRef]
- Gawade, S.P. The effect of venom from the Indian tropical wasp Vespa tropica on nerve—Muscle preparations from Drosophila larvae. Toxicon 1983, 21, 882–886. [Google Scholar] [CrossRef]
- Lee, S.Y.; Park, N.G.; Choi, M.-U. Effects of mastoparan B and its analogs on the phospholipase D activity in L1210 cells. FEBS Lett. 1998, 432, 50–54. [Google Scholar] [CrossRef] [Green Version]
- Argiolas, A.; Pisano, J.J. Isolation and characterization of two new peptides, mastoparan C and crabrolin, from the venom of the European hornet, Vespa crabro. J. Biol. Chem. 1984, 259, 10106–10111. [Google Scholar] [CrossRef]
- Puri, N.; Roche, P.A. Mast cells possess distinct secretory granule subsets whose exocytosis is regulated by different SNARE isoforms. Proc. Natl. Acad. Sci. USA 2008, 105, 2580–2585. [Google Scholar] [CrossRef] [Green Version]
- Chen, W.; Yang, X.; Yang, X.; Zhai, L.; Lu, Z.; Liu, J.; Yu, H. Antimicrobial peptides from the venoms of Vespa bicolor Fabricius. Peptides 2008, 29, 1887–1892. [Google Scholar] [CrossRef]
- Mendes, M.A.; de Souza, B.M.; Palma, M.S. Structural and biological characterization of three novel mastoparan peptides from the venom of the neotropical social wasp Protopolybia exigua (Saussure). Toxicon 2005, 45, 101–106. [Google Scholar] [CrossRef]
- Sforça, M.L.; Oyama, S.; Canduri, F.; Lorenzi, C.C.B.; Pertinhez, T.A.; Konno, K.; Souza, B.M.; Palma, M.S.; Ruggiero Neto, J.; Azevedo, W.F.; et al. How C-Terminal Carboxyamidation Alters the Biological Activity of Peptides from the Venom of the Eumenine Solitary Wasp. Biochemistry 2004, 43, 5608–5617. [Google Scholar] [CrossRef] [PubMed]
- Pathak, N.; Salas-Auvert, R.; Ruche, G.; Janna, M.-H.; McCarthy, D.; Harrison, R.G. Comparison of the effects of hydrophobicity, amphiphilicity, and α-helicity on the activities of antimicrobial peptides. Proteins Struct. Funct. Bioinform. 1995, 22, 182–186. [Google Scholar] [CrossRef] [PubMed]
- Panahi Chegini, P.; Nikokar, I.; Tabarzad, M.; Faezi, S.; Mahboubi, A. Effect of Amino Acid Substitutions on Biological Activity of Antimicrobial Peptide: Design, Recombinant Production, and Biological Activity. Iran. J. Pharm. Res. IJPR 2019, 18, 157–168. [Google Scholar] [CrossRef] [PubMed]
- Čeřovský, V.; Slaninová, J.; Fučík, V.; Hulačová, H.; Borovičková, L.; Ježek, R.; Bednárová, L. New potent antimicrobial peptides from the venom of Polistinae wasps and their analogs. Peptides 2008, 29, 992–1003. [Google Scholar] [CrossRef] [PubMed]
- de Souza, B.M.; Dos Santos Cabrera, M.P.; Neto, J.R.; Palma, M.S. Investigating the effect of different positioning of lysine residues along the peptide chain of mastoparans for their secondary structures and biological activities. Amino Acids 2011, 40, 77–90. [Google Scholar] [CrossRef]
- Incamnoi, P.; Patramanon, R.; Thammasirirak, S.; Chaveerach, A.; Uawonggul, N.; Sukprasert, S.; Rungsa, P.; Daduang, J.; Daduang, S. Heteromtoxin (HmTx), a novel heterodimeric phospholipase A2 from Heterometrus laoticus scorpion venom. Toxicon 2013, 61, 62–71. [Google Scholar] [CrossRef] [PubMed]
- Thévenet, P.; Shen, Y.; Maupetit, J.; Guyon, F.; Derreumaux, P.; Tufféry, P. PEP-FOLD: An updated de novo structure prediction server for both linear and disulfide bonded cyclic peptides. Nucleic Acids Res. 2012, 40, W288–W293. [Google Scholar] [CrossRef] [PubMed] [Green Version]
- Passarini, I.; Rossiter, S.; Malkinson, J.; Zloh, M. In Silico Structural Evaluation of Short Cationic Antimicrobial Peptides. Pharmaceutics 2018, 10, 72. [Google Scholar] [CrossRef] [Green Version]
- Souza, B.M.; Mendes, M.A.; Santos, L.D.; Marques, M.R.; César, L.M.M.; Almeida, R.N.A.; Pagnocca, F.C.; Konno, K.; Palma, M.S. Structural and functional characterization of two novel peptide toxins isolated from the venom of the social wasp Polybia paulista. Peptides 2005, 26, 2157–2164. [Google Scholar] [CrossRef]
- Anunthawan, T.; de la Fuente-Núñez, C.; Hancock, R.E.W.; Klaynongsruang, S. Cationic amphipathic peptides KT2 and RT2 are taken up into bacterial cells and kill planktonic and biofilm bacteria. Biochim. Biophys. Acta (BBA) Biomembr. 2015, 1848, 1352–1358. [Google Scholar] [CrossRef] [Green Version]

| Peptides | Sequences | AA | Molecular Weight (Da) | Charge | %H | H | μH |
|---|---|---|---|---|---|---|---|
| MpVT | INLKAIAAFAKKLI | 14 | 1513.95 | +3 | 71.43 | 0.590 | 0.403 |
| MpVT1 | INLKAIAAFAKKFI | 14 | 1547.96 | +3 | 71.43 | 0.596 | 0.409 |
| MpVT3 | INLKAIAAFAKALI | 14 | 1456.85 | +2 | 78.57 | 0.683 | 0.361 |
| MpVT4 | KAIAAFAKKFI | 11 | 1207.54 | +3 | 72.73 | 0.495 | 0.611 |
| MpVT5 | KAIAAFAKKFFI | 12 | 1354.71 | +3 | 75.00 | 0.603 | 0.411 |
| MpVT6 | KAIAAFAKALFI | 12 | 1263.60 | +2 | 83.33 | 0.704 | 0.370 |
| MpVT7 | KAIAAFAAKLFI | 12 | 1263.60 | +2 | 83.33 | 0.704 | 0.321 |
| Peptides | % Content in Water | % Content in 40% TFE | ||
|---|---|---|---|---|
| α-Helix | β-Sheet | α-Helix | β-Sheet | |
| MpVT | 11.67 | 4.74 | 95.22 | 0.02 |
| MpVT1 | 8.96 | 6.6 | 95.22 | 0.02 |
| MpVT3 | 8.96 | 6.39 | 95.34 | 0.02 |
| MpVT4 | 2.04 | 9.36 | 95.16 | 0.01 |
| MpVT5 | 2.04 | 9.95 | 95.23 | 0.01 |
| MpVT6 | 1.51 | 9.38 | 94.64 | 0.01 |
| MpVT7 | 1.51 | 8.95 | 95.50 | 0.01 |
| Microorganism | MIC (μg/mL) | ||||||
|---|---|---|---|---|---|---|---|
| MpVT | MpVT1 | MpVT3 | MpVT4 | MpVT5 | MpVT6 | MpVT7 | |
| P. aeruginosa ATCC 27,853 (DMST 4739) | 25.00 | 6.25 | 6.25 | 25.0 | >50.00 | >50.00 | >50.00 |
| S. aureus ATCC25923 | 50.00 | 12.50 | 50.00 | >50.00 | >50.00 | >50.00 | >50.00 |
| B. subtilis ATCC663 | 25.00 | 3.125 | 12.50 | >50.00 | >50.00 | >50.00 | 50.00 |
| E. coli 0157:H7 | 50.00 | 6.25 | 50.00 | >50.00 | >50.00 | >50.00 | >50.00 |
| E. coli DH5α | 3.125 | 0.39 | 0.78 | 25.00 | 6.25 | 12.50 | 6.25 |
| K. pneumoniae ATCC27736 (DMST4739) | 25.00 | 6.25 | 25.00 | >50.00 | >50.00 | >50.00 | >50.00 |
Publisher’s Note: MDPI stays neutral with regard to jurisdictional claims in published maps and institutional affiliations. |
© 2022 by the authors. Licensee MDPI, Basel, Switzerland. This article is an open access article distributed under the terms and conditions of the Creative Commons Attribution (CC BY) license (https://creativecommons.org/licenses/by/4.0/).
Share and Cite
Rungsa, P.; Peigneur, S.; Jangpromma, N.; Klaynongsruang, S.; Tytgat, J.; Daduang, S. In Silico and In Vitro Structure–Activity Relationship of Mastoparan and Its Analogs. Molecules 2022, 27, 561. https://doi.org/10.3390/molecules27020561
Rungsa P, Peigneur S, Jangpromma N, Klaynongsruang S, Tytgat J, Daduang S. In Silico and In Vitro Structure–Activity Relationship of Mastoparan and Its Analogs. Molecules. 2022; 27(2):561. https://doi.org/10.3390/molecules27020561
Chicago/Turabian StyleRungsa, Prapenpuksiri, Steve Peigneur, Nisachon Jangpromma, Sompong Klaynongsruang, Jan Tytgat, and Sakda Daduang. 2022. "In Silico and In Vitro Structure–Activity Relationship of Mastoparan and Its Analogs" Molecules 27, no. 2: 561. https://doi.org/10.3390/molecules27020561
APA StyleRungsa, P., Peigneur, S., Jangpromma, N., Klaynongsruang, S., Tytgat, J., & Daduang, S. (2022). In Silico and In Vitro Structure–Activity Relationship of Mastoparan and Its Analogs. Molecules, 27(2), 561. https://doi.org/10.3390/molecules27020561

